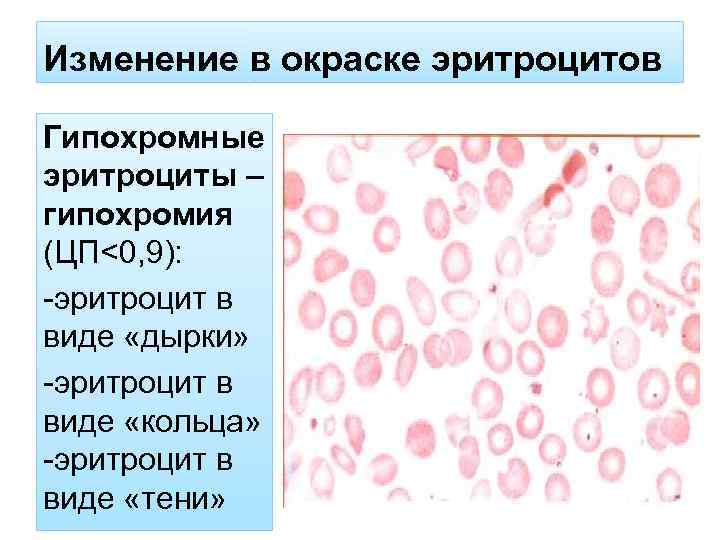
Изменение в окраске эритроцитов Гипохромные эритроциты – гипохромия (ЦП˂0, 9): -эритроцит в виде «дырки»

Тема лекции анемии ПФ - копия.pptx
- Количество слайдов: 33

Тема лекции: «Типовые нарушения системы крови. Общее учение об анемиях» План лекции 1. Определение понятия «Анемия» . 2. Методы изучения анемий. 3. Патологические формы эритроцитов. 4. Принципы классификаций анемий.

Нормальный уровень эритроцитов у детей • • • новорожденный 3, 9 -5, 5 х 1012/л с 1 по 3 -й день 4, 0 -6, 6 х 1012/л в 1 неделю 3, 9 -6, 3 х 1012/л во 2 неделю 3, 6 -6, 2 х 1012/л в 1 месяц 3, 0 -5, 4 х 1012/л во 2 месяц 2, 7 -4, 9 х 1012/л с 3 по 6 месяц 3, 1 -4, 5 х 1012/л с 6 месяцев до 2 лет 3, 7 -5, 3 х 1012/л с 2 -х до 6 лет 3, 9 -5, 3 х 1012/л с 6 до 12 лет 4, 0 -5, 2 х 1012/л в 12 -18 лет мальчики 4, 5 -5, 5 х 1012/л в 12 -18 лет девочки 4, 0 -5, 0 х 1012/л

Норма гемоглобина у детей До 2 -х недель 134 - 198 г/л с 2 -х до 4, 3 недель 107 - 171 г/л с 4, 3 до 8, 6 недель 94 - 130 г/л с 8, 6 недель до 4 месяцев 103 – 141 г/л в 4 до 6 месяцев 111 - 141 г/л с 6 до 9 месяцев 114 – 140 г/л с 9 до 1 года 113 – 141 г/л с 1 года до 5 лет 100 – 140 г/л с 5 лет до 10 лет 115 - 145 г/л с 10 до 12 лет 120 - 150 г/л

Нормативы эритроцитов и гемоглобина в единице объема крови Эритроциты (RBC – red blood cells красные кровяные тельца ) у мужчин – 4, 5 -5, 5 · 1012/л или тер/л у женщин – 4 -5 · 1012/л или тер/л Гемоглобин (HGB - Hb, hemoglobin) у мужчин – 130 -170 г/л у женщин – 120 -150 г/л MCH (mean contains hemoglobin — среднее содержание гемоглобина в эритроците в абсолютных единицах (норма 25— 36 пг/кг (pg)), пропорциональное отношению «гемоглобин/количество эритроцитов» . Цветовой показатель крови в старых анализах. ЦП=MCH*0. 03 ЦП= гемоглобин/количество эритроцитов · 0, 03 В норме 0, 9 -1, 1

Схема кроветворения

Ретикулоциты или полихроматофильные эритроциты Ретикулоцитов в норме в периферической крови – 210 ‰ или 0, 2 -1, 0%. Выявляются при суправитальной окраске красителем бриллианткрезилбрау. Полихроматофильных эритроцитов в норме – 0 -6‰ или 0, 6%. Выявляются при окраске по Райту или по Романовскому-Гимзе

Эритроцит Средний диаметр эритроцитов – 6, 7 -7, 7 мкм, а средний объем клетки (СОК или МСV – mean corpuscular volume) – 80 -100 мкм 3 (fl-фемтолитрах). Средняя концентрация Hb в эритроците (МСНС – mean corpuscular hemoglobin concentration) – 310 -370 г/л

Анемия – общий типовой патологический процесс системы эритроцитов, который встречается при большинстве заболеваний и характеризуется тремя группами взаимосвязанных признаков: - уменьшение количества гемоглобина и эритроцитов в единице крови - качественные нарушения эритроцитов или гемоглобина - нарушение многочисленных функций организма в связи с развитием гемической гипоксии

Патологические формы красной крови Дегенеративные формы эритроцитов ( «полом» в системе эритроцитов) Регенеративные формы эритроцитов (защитная реакция костного мозга) • Изменение в окраске эритроцитов • Изменение величины эритроцитов – анизоцитоз • Изменение формы эритроцитов – пойкилоцитоз • Необычные формы развития • «Ядерные» регенеративные формы • «Цитоплазменные» регенеративные формы (молодые эритроциты с базофильной субстанцией)

Изменение в окраске эритроцитов Нормохромные эритроциты – нормохромия (ЦП=0, 9 -1, 1)
Изменение в окраске эритроцитов Гипохромные эритроциты – гипохромия (ЦП˂0, 9): -эритроцит в виде «дырки» -эритроцит в виде «кольца» -эритроцит в виде «тени»

Изменение в окраске эритроцитов Гиперхромные эритроциты – гиперхромия (ЦП˃1, 1): Эритроциты без просветления и с просветлением

Изменение в окраске эритроцитов Анизохромные эритроциты – анизохромия – в периферической крови присутствуют гипохромные, гиперхромные и нормохромные эритроциты

Изменение величины эритроцитов - анизоцитоз • Физиологический анизоцитоз Мезоциты 6. 7 -7. 7 мкм 68% Микроциты <6. 7 мкм 15. 5% Макроциты >7. 7 – 9, 5 мкм 16, 5% • Патологический анизоцитоз Анизоцитоз-микроцитоз >50% Анизоцитоз- макроцитоз >50% Анизоцитоз-мегалоцитоз

Изменение формы эритроцитов пойкилоцитоз 1) Наличие в мазке крови эритроцитов разной формы( при регенеративных анемиях) 2) Резкий пойкилоцитоз (при тяжелых анемиях) 3) Изопойкилоцитоз (единонаправленные изменения формы эритроцитов – при наследственных анемиях)

Пойкилоциты Эхиноциты сферические клетки Акантоцит - клетки на поверхности имеют зубчатую форму

Пойкилоциты Стоматоциты (гидроциты) клетки с увеличенной на 2030% объемом и площадью поверхности, имеют щелевидную форму центрального просвета (пэллора). Серповидные клетки (дрепаноциты) характерны для серповидно-клеточной анемии, а также других гемоглобинопатий, содержат гемоглобин S,

Пойкилоциты Мишеневидные клетки (кодоциты) Кодоциты характерны для альфа- и бета-талассемии, гемоглобинопатии С и S, Эллиптоциты (овалоциты) - составляют в норме менее 1% клеток. Однородность популяции (более 25%) характерна для наследственного эллиптоцитоза.

Необычные формы развития Исследование костного мозга при В 12 -дефицитной анемии: выявляется мегалобластический эритропоэз. Длинной стрелкой показан мегалобласт, короткой – овальный макроцит Эритробласт встречается при: 1. Эритролейкозе 2. Гемолитической болезн

Анизоцитоз, пойкилоцитоз, гипохромия, гиперхромия

Регенеративные формы эритроцитов «Ядерные» : пронормоциты, нормоциты: базофильные, полихроматофильные, оксифильные; эритроциты с т. Жоли, эритроциты с к. Кабо

Регенеративные формы эритроцитов (защитная реакция костного мозга) «Цитоплазменные» регенеративные формы (молодые эритроциты с базофильной субстанцией) • Полихромазия – увеличение полихроматофильных эритроцитов (норма 0 -6 ‰ )> 6‰ • Ретикулоцитоз – увеличение ретикулоцитов (норма 2 -10 ‰ ) > 10‰


Патологические формы красной крови Выраженные гипохромия эритроцитов, анизоцитоз, пойкилозитоз, шизоцилы, присутствие полихроматоф илов.

Различные формы эритроцитов крови при анемических Рис. 2. Анизопойкилоцитоз, гиперхромия, полихроматофилия эритроцитов. Рис. 3. Мегалобластическое кроветворение Мегалобласты: 1 -4. Рис. 5. Эритроциты с базофильной пунктацией. Рис. 7. Пойкилоцитоз, анизоцитоз. Рис. 8. Кровь ребенка при анемии Якша — Гайема: 1 — базофильный мегалобласт; 2 — полихроматофильный эритроцит; 3 — нейтрофильный миелоцит; 4 — полихроматофильный нормобласт; 5 — палочкоядерный нейтрофил. Пойкилоцитоз, анизоцитоз. Рис. 9. Кровь ребенка при анемии на почве чрезмерного употребления козьего молока: 1 — лимфоцит; 2 — полихроматофильный эритроцит; 3 — базофильный нормобласт; 4 — полихроматофильный нормобласт; 5 — полихроматофильный пойкилоцит (эритроцит); 6 — кровяные пластинки. Пойкилоцитоз, анизоцитоз.

Классификация анемий по этиологии 1. Приобретенные анемии 2. Наследственные анемии

Классификация анемий по патогенезу 1. Постгеморрагичесские анемии 2. Гемолитические анемии 3. Анемии от недостаточного образования эритроцитов

Классификация анемий по патогенезу с учетом причинных факторов ( Г. А. Алексеев). 1. 2. 3. Постгеморрагичсске анемии 1) острые ( после острой кровопотери) 2) хронические ( после хронической кровопотери) Гемолитические анемии 1) Приобретенные ( с внутрисосудистым гемолизом) 2) Наследственные (с внесосудистым гемолизом) Анемии от недостаточного образования эритроцитов 1) дефицитные 2) миелотоксические З) гипо- апластические 4) метапластические

Классификации анемий Классификация анемий по типу кроветворения (Эрлих) 1. 2. Анемии с эритробластическим типом кроветворения Анемии с мегалобластическим типом кроветворения Классификация анемий по цветовому показателю 1. 2. 3. Нормохромные FI = 0. 9 -1. 1 Гипохромные. FI < 0. 9 (ЖДА, сидеробластная анемия, некоторые гемолитические анемии и при х. заболеваниях) Гиперхромные FI > 1. 1(В 12 -ФДА и некоторые гемолитические анемии)

Классификация анемий по функциональному состоянию костного мозга (Г. А. Кассирский) 1. Гипорегенераторные (ретикулоциты крови >10‰ до 20 ‰) (дефицитные, гипо- и метапластически анемии) 2. Регенераторные (ретикулоциты крови >20‰ до 100 ‰) (острые постгеморрагические анемии) 3. Гиперрегенераторные (ретикулоциты крови >100‰) (все гемолитические анемии) 4. Арегенераторные (ретикулоциты крови <2‰) (апластические анемии) 5. Дисрегенераторные: § рецидив: ретикулоциты < 2‰, 0‰, мегалобласты, мегалоциты; § ремиссия: ретикулоциты >10 ‰ до 20‰, единичные мегалоциты (В 12 – ФДА и ФДА)

Классификация анемий по среднему объему клеток (СОК или МСV) • Анемии микроцитарные - МСV˂6, 7 мкм (ЖДА, сидеробластная анемия (СБА), талассемия и некоторые анемии при АХЗ) • Анемии макроцитарные - МСV˃7, 7 мкм (В 12 ФДА и ФДА, анемии при хронических заболеваниях печени, алкоголизме, микседеме) • Анемии нормоцитарные – МСV=6, 7 -7, 7 мкм (гипо- и апластические анемии, ОПА, для сфероцитоза Минковского-Шоффара и АХЗ)

Литература для подготовки лекции 1. Литвицкий П. Ф. Патофизиология, учебник в двух томах. Москва, 2002. , ΙΙт. , с 19 -45 2. Порядин Г. В. Патофизиология курс лекций: учебное пособие -. : ГЭОТАР-Медиа, 2012. , с. 102128 3. Зайко Н. Н. , Быця Ю. В. Патологическая физиология, М. , «МЕДпресс-информ» , 2007 г. , с. 356 -370 4. Шанин В. Ю. Патофизиология. СПб: ЭЛБИСПб, 2005. 5. Войнов В. А. Атлас по патофизиологи: Учебное пособие. - М. : Медицинское информационное агентство, 2004. , с. 123 -134

Литература для студентов • Новицкий В. В. , Гольдберг Е. Д. , Патологическая физиология, Томск, 2001. , с. 407 -418 • Воложин А. И. , Порядин Г. В. Патологическая физиология, М. , 2007, в трёх томах. Том 3. с. 89 -106 • «Патофизиология» П. Ф. Литвицкий, М. . : ГЭОТАР - Медиа, 2008 г. , с. 307 -314 • Патологическая физиология: пособие для вузов / А. Д. Адо, М. А. Адо – М. : Дрофа, 2009. , с. 491 -503 • Адо А. Д. , Патологическая физиология, М. , 2000, с. 457 -467.
Тема лекции анемии ПФ - копия.pptx